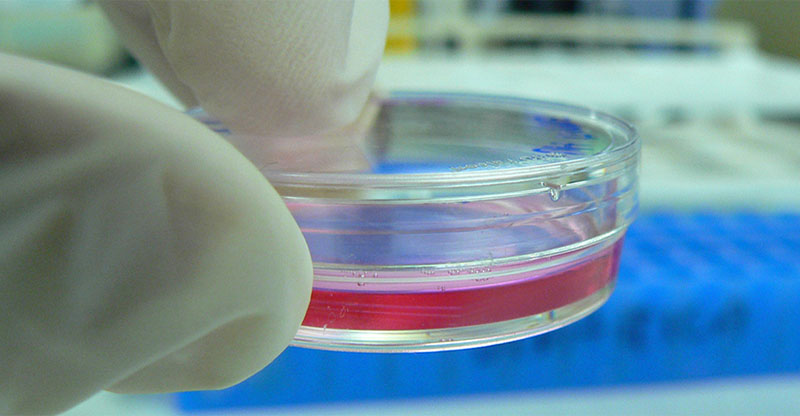
Cultivar órganos para transplantes

Un estudio reciente, llevado a cabo por investigadores del Instituto de Ciencias Médicas de la Universidad de Tokio, en colaboración con la Facultad de Medicina de la Universidad de Stanford, ha logrado ofrecer un nuevo enfoque en la medicina regenerativa. Los científicos han sido capaces de cultivar órganos de una especie de animal concreta en el cuerpo de otro animal, para, posteriormente ser trasplantados.
Este estudio, publicado en la revista Nature, muestra que es posible trasplantar islotes pancreáticos, cultivados en ratas, a ratones afectos de diabetes tipo 1. Además, estos grupos de células, productoras de insulina han logrado generar su actividad normal durante tiempos prolongados.
Lo principal de esta investigación es la evidencia de que es posible que los órganos crezcan en el cuerpo de una especie concreta para ser trasplantados en otra. Esto, obviamente, abre una nueva ventana a la creación de tejidos y órganos humanos para evitar las largas listas de espera de los trasplantes. No obstante, todavía queda mucho camino por recorrer para poder aplicar esta técnica en humanos.
Cultivar órganos de rata para ratones diabéticos
En las situaciones en las que los fármacos no son capaces de estabilizar la diabetes tipo 1, uno de los tratamientos pasa por trasplantar islotes pancreáticos. El problema es la dificultad que surge para encontrar un donante óptimo. Este fue el enfoque del estudio publicado recientemente.
Los científicos implantaron células madre pluripotentes de ratón en embriones de rata. Estas células tienen la peculiaridad de que pueden transformarse en cualquier tipo de célula. Además, pueden fabricar infinidad de células nuevas. Las ratas que se usaron para desarrollar la investigación fueron modificadas a nivel genético para que no desarrollaran su páncreas propio. De esta forma, tuvieron que recibir las células de los ratones para hacerlo.
Cuando las ratas habían crecido, los responsables del estudio se encargaron de trasplantar los islotes de células productoras de insulina a los ratones afectos de diabetes. Los resultados muestran la eficacia y efectividad de una técnica muy novedosa. Los ratones pudieron normalizar sus niveles de glucosa en sangre. Lo más curioso es que un año después de haber trasplantado los islotes, su situación seguía siendo positiva y normalizada. Además, los investigadores hacen hincapié en que solo fue necesario el uso de inmunosupresores durante cinco días después del trasplante.
Nuevo enfoque para tratar la diabetes
Las investigaciones llevadas a cabo por los equipos de estudio de ambas universidades muestran una ventana nueva de tratamiento para pacientes con diabetes. Tras diez meses escogieron a un grupo de estos ratones y les eliminaron los islotes. Así, buscaron la presencia de células de rata en su organismo y la sorpresa fue que el sistema inmunológico del animal se había deshecho de ellas.
Esto abre las puertas a las investigaciones para el trasplante de órganos a humanos, previamente cultivados en animales. Aunque, obviamente, es importante que los científicos ajusten su técnica para poder trabajar en animales más grandes y compatibles con humanos.
Otra cuestión importante es que, durante el estudio, los ratones no contaron con tumores ocasionados por las células madres pluripotentes. Hay que tener en cuenta que la plasticidad de estas células puede convertirse en el caldo de cultivo perfecto para el desarrollo de tumores.
Diana terapéutica para la diabetes
La diabetes es una enfermedad metabólica que impide la correcta formación de insulina. Esta última es una hormona, necesaria para regular los niveles de azúcar en la sangre. La prevalencia de esta patología es altísima y parece que va en aumento. De ahí que sea tan importante encontrar métodos de tratamiento efectivos.
El trasplante de islotes funcionales de páncreas es una de las opciones de tratamiento, cuando los fármacos no consiguen atajar la afección. El problema de esto es que es necesario encontrar donantes compatibles con los afectos, para evitar el rechazo. En este sentido, este estudio sobre la forma de cultivar órganos podría convertirse en un primer paso para tratar estas enfermedades, así como para evitar las listas de espera de los trasplantes de órganos.